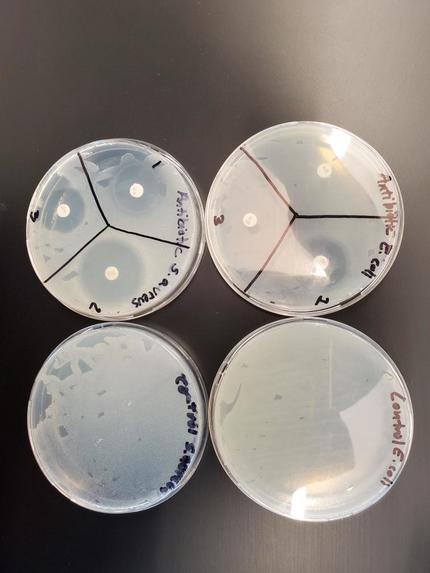
Antimicrobial Filament for 3D printing – screenshot 1

Inspiration
We think that college students can innovate, create, and make solutions to real world problems when they are given the right mentorship and guidance. Giving back to our community is always a priority especially during this pandemic situation.
What it does
We developed a formula to make antimicrobial materials to produce filaments for 3D printing. Unlike some products in the market that only claim antibacterial characteristics, ours on the other hand, has been tested in our lab and it shows antimicrobial efficacy. We can also provide service to test antimicrobial efficacy on other products. In addition, We have an X-ray machine to quality control our materials by examining the concentration of the active ingredients such as silver or zinc. Our ingredients are FDA food contact compliant and are heat resistant. Our material can be used also to make a face shield head band during this pandemic situation to be used by first line health and food workers.
How I built it
We made our antimicrobial gadget by using an auto-cad program and 3D printed as a prototype. Our design is inspired from an already existing stick in the market which is made from metal.
What's next for Antimicrobial Filament for 3D printing
We would like to work with 3D printing companies and maker spaces by supplying them our material to be used to 3D print antimicrobial gadgets, face shields head band,
Built With
- 3dprinting
- autodesk
- extrusion
- ingredients
- polymer
- x-ray
Log in or sign up for Devpost to join the conversation.